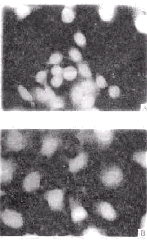

蟾蜍灵诱导人胃癌细胞凋亡的实验研究
作者:陈小义 徐瑞成 陈莉 张敏 卢青 吴晓霞
单位:陈小义(中国人民武装警察部队医学院,天津 300162);徐瑞成(中国人民武装警察部队医学院,天津 300162);陈莉(中国人民武装警察部队医学院,天津 300162)张敏(中国人民武装警察部队医学院,天津 300162);卢青(中国人民武装警察部队医学院,天津 300162);吴晓霞(中国人民武装警察部队医学院,天津 300162)
关键词:胃癌细胞;细胞凋亡;蟾蜍灵
基础医学与临床000515
摘要 :用MTT 法、 形态学观察法、 DNA 电泳和流式细胞仪观察蟾蜍灵(Bufalin)诱导的胃癌细胞凋亡。结果表明,0.01mmol/L 蟾蜍灵作用 MGc-803细胞48 h,即可显著抑制细胞生长,IC50值约为0.1 mmol/L。琼脂糖凝胶电泳获得梯形图谱,流式细胞仪DNA直方图上出现典型的亚二倍体峰,凋亡主要发生在G1/G0期,细胞凋亡率随药物浓度和作用时间的增加而增高。以上结果提示,bufalin对胃癌细胞具有很强的抑制作用,诱导凋亡是其主要作用机制之一。
, http://www.100md.com
中图分类号:Q255 文献标识码 :A
文章编号:1001-6325(2000)05-0050-04
Apoptosis of gastric cancer cells induced by bufalin
CHEN Xiao-yi,XU Rui-cheng,CHEN Li,et al.
(Medical College of Chinese People's Armed Police Forces,Tianjin 300162,China)
Abstract: In the present paper,the mechanism of actions of bufalin on inhibiting human gastric cancer cells was studied.MGc-803 cells were treated with bufalin at different concentrations and cell growth was analysed by MTT assay.Cell apoptosis was evaluated by light microscopy,electric microscopy,flow cytometry and DNA argorose gel eletronphoresis.It was showed that bufalin at concentration of 0.01mmol/L inhibited MGc-803 cell growth remarkably,the IC50 was about 0.1 mmol/L.Further study showed that bufalin induced MGc- 803 cell death characterized by apoptotic phenotypes,DNA content changes and chromosome DNA fragmentation. Bufalin showed a remarkable cell cycle specificity in inducing apoptosis in G1 phase.The induction of apoptosis would be a very important mechanism of bufalin in treatment of gastric cancer.
, http://www.100md.com
Key words: bufalin;gastric cancer cells;apoptosis
蟾酥是传统中药,成分复杂,具有多方面作用, 临床使用蟾酥制剂及相关合剂治疗晚期胃癌,取得良好效果[1], 也有报道蟾酥脂质体对培养的肿瘤细胞有明显的抑制作用[2],但是,蟾酥抑癌有效成分及抑癌机制的研究少见报道。我们用从中华大蟾蜍中提取的蟾蜍灵单质,以离体培养的人低分化胃腺癌细胞系MGc-803细胞为靶细胞,使用光镜、电镜、电泳、MTT 法和流式细胞仪,对蟾蜍灵诱导肿瘤细胞凋亡的作用机制进行探讨。
1 材料与方法
1.1 药物
蟾蜍灵(bufalin,FW386)购自Sigma公司, 用无水乙醇配成储备液,过滤除菌,用D-hank's液稀释,乙醇终浓度小于0.1%。
, http://www.100md.com
1.2 细胞培养
人胃癌细胞系MGc-803引自北京市肿瘤防治研究所,常规培养于含10%胎牛血清的DMEM培养液。 细胞接种后于指数生长期进行不同浓度的蟾蜍灵处理,相应时间后取材。细胞计数采用台盼蓝染色法。
1.3 细胞形态学观察
1.3.1倒置光显微镜观察原位培养细胞的形态学改变。
1.3.2荧光显微镜观察核染色质和胞浆RNA的改变,应用吖啶橙染色法。
1.3.3透射电镜观察细胞超微结构的变化 :样品处理按文献[3]进行。
1.4 MTT法检测蟾蜍灵的抑制作用
将 MGc-803 胃癌细胞悬液 (104cells/mL)接种于96孔培养板,24h后加药,检测法按文献[4]进行。
, 百拇医药
1.5 凋亡细胞DNA的琼脂糖凝胶电泳
收集2×106个细胞,PBS洗涤1次, 移入eppendorf管,重悬于20mL PBS,加入400mL细胞裂解液(1% NP-40、20 mmol EDTA、50 mmol Tris Cl,pH7.5),混匀,裂解30 min(镜下检查),8 000×g离心5 min,转移上清至另一eppendorf管中,并向其中加入10% SDS 至终浓度为1%,加入RNase A至终浓度为50 mg/L,置56 ℃,2 h;再加入蛋白酶K至终浓度25 mg/L,37 ℃,2 h,沉淀DNA,样品溶于少量TE中,1.5%琼脂糖凝胶(含0.5 mg/L EB),50 V,电泳4 h,紫外灯下照相。
1.6 细胞周期时相中DNA含量的测定
收集细胞1×106个,PBS洗两次, 70%冰冻乙醇固定,4 ℃保存。 经碘化丙啶 ( PI,1g/L) 染色, 在Becton/Dickinson FACS420型流式细胞仪上检测。并根据DNA含量直方图中出现的“亚G1峰”计算凋亡细胞百分数。
, 百拇医药
2 结果
2.1 蟾蜍灵对肿瘤细胞生长的抑制作用
蟾蜍灵处理48 h,明显抑制 MGc-803细胞生长,并随着药物浓度的增加,抑制率也增大,蟾蜍灵对MGc-803 的IC50值在0.01~0.1 mmol/L之间(表1)。
2.2 蟾蜍灵诱导肿瘤细胞凋亡
2.2.1 细胞形态学改变:倒置显微镜下,MGc-803细胞呈梭形或多边形,加入蟾蜍灵,细胞变圆,细胞内颗粒增多,细胞透明度下降,体积缩小, 可见凋亡小体形成,分布于细胞残体周围;爬片细胞经吖啶橙染色,在荧光显微镜下可见,对照组细胞核呈黄绿色,胞浆染成橙红色;而药物处理组细胞变圆,核碎裂,胞浆橙红色变浅(图1);电镜照片(图2)显示:凋亡早期,染色质发生边移现象,沿核膜内侧分布,细胞器完整;后期,核膜瓦解,核凝缩,出现变性空泡,细胞器减少,细胞尚保持结构。
, 百拇医药
2.2.2 DNA凝胶电泳观察到典型的DNA 梯状带:细胞凋亡时,由于核酸内切酶活化,染色质在核小体之间断裂,产生寡聚核小体, 电泳带谱表现为特征性的梯状带(DNA ladder)。0.01和0.1 mmol/L 蟾蜍灵处理MGc-803,在48 h出现清晰的DNA梯状带,而未处理的对照组细胞不显示DNA梯状带。
2.2.3 流式细胞仪分析结果:不同浓度蟾蜍灵处理细胞,一定时间后,出现相当比例的DNA含量小于二倍体的亚G1凋亡峰,在6、12、24和48 h,凋亡率逐步升高(表2),细胞周期也发生明显变化,G1期细胞数量逐渐减少(图3), 同期台盼蓝染色阳性细胞数分别为2.1%、4.7%、8.1%和12.3%。
图 1 吖啶橙染色示细胞染色质和RNA 的变化
Fig 1 The changes of chromatin and RNA
, 百拇医药
stained by acridine orange
A control ;B Treatment with 0.1 m mol/L bufalin for 24h;
fluorescein microscopy ×200
图 2 电镜观察细胞超微结构的变化
Fig 2 MGc-803 cells treated with bufalin (2b 2c EM
7500)compared with control cells(2a EM 7500)
Apoptotic cells shrinked cell became smaller chromatin accumu-
, 百拇医药
lated under nuclear membrane (2b)the electron density of apoptotic
tumor cells increased apoptotic body formed(2c)
图 3 流式细胞术分析细胞周期的变化
Fig 3 The changes of cell cycle analysed
by flow cytometry
表 1 蟾蜍灵抑制胃癌细胞MGc-803 生长
Table 1 Growth inhibition of gastric cancer cells
, 百拇医药
induced by bufalin concentration
Avalue
rateofinhibition
(μmol/L)
bufalin
control
blank
(%)
0.001
1.32±0.14
1.43±0.10
, 百拇医药 0.44±0.06
11.1
0.01
1.03±0.13*
40.4
0.1
0.77±0.07**
66.7
1.0
0.48±0.07**
96.0
表 2 蟾蜍灵作用胃癌细胞MGc-803 调亡率
, 百拇医药
Table 2 Apoptotic rate of gastric cancer cells induced by bufalin concentration(m
mol/L)
apoptoticrate(%)
rateofinhibition
0.00
1.43±0.04
2.21±0.07
4.61±0.21
6.03±0.21
0.01
, 百拇医药
6.15±1.13*
10.22±0.69#
16.74±0.74#
26.24±1.48#
0.10
10.59±0.90**
21.01±1.82#
32.43±1.12
43.17±1.31
3 讨论
, 百拇医药
蟾酥是我国的传统中药,临床治疗胃癌获得了显著疗效,胃癌不仅是细胞增殖和分化异常的疾病,也是细胞凋亡异常的疾病[5],因此,筛选能够诱导胃癌细胞凋亡的有效成分,具有重要的实用价值。
我们实验发现蟾蜍灵与MGc-803细胞共育时,细胞增殖明显受到抑制,细胞脱落圆形小体,数目随时间递增,而台盼蓝染色阳性细胞保持较低的水平;经形态学、细胞学和DNA片段检查等多方面证实, 蟾蜍灵可有效地诱导胃癌细胞凋亡,凋亡早期,凋亡小体(apoptotic body) 及细胞残体为台盼蓝拒染,后期,阳性细胞数增多可能与凋亡后的继发性坏死有关。蟾蜍灵作用于MGc-803细胞时,G1期细胞数目下降,在DNA直方图上观察到典型的亚G1峰,可见蟾蜍灵主要诱导G1期细胞凋亡。
蟾蜍灵抑癌作用的机制还不是很清楚。Numazawa等[6]报道低浓度(0.001-0.005 mmol/L)蟾蜍灵能诱导肿瘤细胞分化;Mashuda等[7]用1 mmol/L蟾蜍灵处理白血病HL60细胞15 min,然后撤药,继续培养15 h, 检测到细胞生存率下降和DNA梯形条带, 提示蟾蜍灵处理后, 细胞凋亡信号立即启动 ;Hashimoto等[8]报道蟾蜍灵降低细胞拓扑异构酶Ⅱ的活性,并检测到DNA裂解,用0.1 mmol/L蟾蜍灵预处理HL60细胞6 h,能增强顺铂和维甲酸的诱导凋亡作用;Jing等[9]用1mmol/L 蟾蜍灵处理人正常单核细胞和多形核细胞24 h,没有观察到细胞凋亡,蟾蜍灵选择性地抑制肿瘤细胞生长;另外,Lee等[10]发现蟾蜍灵能抑制血管的生成, 抑制肿瘤的血管生成也是其抗癌机制的重要方面。本研究首次发现,0.01 mmol/L及以上浓度的蟾蜍灵能有效地诱导胃癌细胞凋亡,扩展了蟾蜍灵的抗癌癌谱。
, http://www.100md.com
总之,本研究发现蟾蜍灵是一种有效诱导低分化胃腺癌细胞凋亡的药物,并具有细胞周期特异性,蟾蜍灵诱导胃癌细胞凋亡的机制有待于进一步研究。
参考文献:
[1] 杨素娟.蟾蜍及蟾酥的临床应用与研究进展[J].中医药信息,1995,( 5) :12-13.
[2] 田普训等.蟾酥脂质体对人膀胱移行细胞癌BIU-87 作用的体外实验研究[J].中华泌尿外科杂志,1994,15(6):432-435.
[3] Racker DK, Hoffman RE, Fortner JG.Transmission electricmicroscopy :methods of application[M]. Illinois: Charles C Thomas Publisher,1983,14.
, 百拇医药
[4] 温汉平,王小宁,孙华蕴.肿瘤细胞体外药敏试验MTT分析法[J].中华肿瘤杂志,1993,15(6):470-471.
[5] Waston A J M. Necrosis and apoptosis in the gastrointestinal tract[J].Gut,1995,37:165-168.
[6] Numazawa S,Inoue N,Nakura H,et al.A cardiotonic steroid bufalin- induced differentiation of THP-1 cells[J].Biochem Pharmacol,1996,52(2):321-329.
[7] Mashuda Y,Kawazoe N,Nakajo S,et al.Bufalin induces apoptosis and influences the expression of apoptosis- related genes in human leukemia cells[J].Leuk Res,1995,19(8):549-556.
, 百拇医药
[8] Hashimoto S,Jing Y, Kawazoe N, et al. Bufalin reduces the level of topoisomerase Ⅱ in human leukemia cells and affects the cytotoxicity of anticancer drugs[J]. Leuk Res,1997, 21(9): 875-883.
[9] Jing Y,Ohizumi H,Kawazoe N,et al. Selective inhibitory effect of bufalin on growth of human tumor cells in vitro:association with the induction of apoptosis in leukemia HL60cells[J]. Jpn J Cancer Res,1994,85(6):645-651.
[10] Lee DY,Yasuda M,Yamamoto T,et al.Bufalin inhibitits endothelial cell proliferation and angiogenesis in vitro[J].Life Sci,1997,60(2):127-134.
1999-09-04
2000-01-29, 百拇医药
单位:陈小义(中国人民武装警察部队医学院,天津 300162);徐瑞成(中国人民武装警察部队医学院,天津 300162);陈莉(中国人民武装警察部队医学院,天津 300162)张敏(中国人民武装警察部队医学院,天津 300162);卢青(中国人民武装警察部队医学院,天津 300162);吴晓霞(中国人民武装警察部队医学院,天津 300162)
关键词:胃癌细胞;细胞凋亡;蟾蜍灵
基础医学与临床000515
摘要 :用MTT 法、 形态学观察法、 DNA 电泳和流式细胞仪观察蟾蜍灵(Bufalin)诱导的胃癌细胞凋亡。结果表明,0.01mmol/L 蟾蜍灵作用 MGc-803细胞48 h,即可显著抑制细胞生长,IC50值约为0.1 mmol/L。琼脂糖凝胶电泳获得梯形图谱,流式细胞仪DNA直方图上出现典型的亚二倍体峰,凋亡主要发生在G1/G0期,细胞凋亡率随药物浓度和作用时间的增加而增高。以上结果提示,bufalin对胃癌细胞具有很强的抑制作用,诱导凋亡是其主要作用机制之一。
, http://www.100md.com
中图分类号:Q255 文献标识码 :A
文章编号:1001-6325(2000)05-0050-04
Apoptosis of gastric cancer cells induced by bufalin
CHEN Xiao-yi,XU Rui-cheng,CHEN Li,et al.
(Medical College of Chinese People's Armed Police Forces,Tianjin 300162,China)
Abstract: In the present paper,the mechanism of actions of bufalin on inhibiting human gastric cancer cells was studied.MGc-803 cells were treated with bufalin at different concentrations and cell growth was analysed by MTT assay.Cell apoptosis was evaluated by light microscopy,electric microscopy,flow cytometry and DNA argorose gel eletronphoresis.It was showed that bufalin at concentration of 0.01mmol/L inhibited MGc-803 cell growth remarkably,the IC50 was about 0.1 mmol/L.Further study showed that bufalin induced MGc- 803 cell death characterized by apoptotic phenotypes,DNA content changes and chromosome DNA fragmentation. Bufalin showed a remarkable cell cycle specificity in inducing apoptosis in G1 phase.The induction of apoptosis would be a very important mechanism of bufalin in treatment of gastric cancer.
, http://www.100md.com
Key words: bufalin;gastric cancer cells;apoptosis
蟾酥是传统中药,成分复杂,具有多方面作用, 临床使用蟾酥制剂及相关合剂治疗晚期胃癌,取得良好效果[1], 也有报道蟾酥脂质体对培养的肿瘤细胞有明显的抑制作用[2],但是,蟾酥抑癌有效成分及抑癌机制的研究少见报道。我们用从中华大蟾蜍中提取的蟾蜍灵单质,以离体培养的人低分化胃腺癌细胞系MGc-803细胞为靶细胞,使用光镜、电镜、电泳、MTT 法和流式细胞仪,对蟾蜍灵诱导肿瘤细胞凋亡的作用机制进行探讨。
1 材料与方法
1.1 药物
蟾蜍灵(bufalin,FW386)购自Sigma公司, 用无水乙醇配成储备液,过滤除菌,用D-hank's液稀释,乙醇终浓度小于0.1%。
, http://www.100md.com
1.2 细胞培养
人胃癌细胞系MGc-803引自北京市肿瘤防治研究所,常规培养于含10%胎牛血清的DMEM培养液。 细胞接种后于指数生长期进行不同浓度的蟾蜍灵处理,相应时间后取材。细胞计数采用台盼蓝染色法。
1.3 细胞形态学观察
1.3.1倒置光显微镜观察原位培养细胞的形态学改变。
1.3.2荧光显微镜观察核染色质和胞浆RNA的改变,应用吖啶橙染色法。
1.3.3透射电镜观察细胞超微结构的变化 :样品处理按文献[3]进行。
1.4 MTT法检测蟾蜍灵的抑制作用
将 MGc-803 胃癌细胞悬液 (104cells/mL)接种于96孔培养板,24h后加药,检测法按文献[4]进行。
, 百拇医药
1.5 凋亡细胞DNA的琼脂糖凝胶电泳
收集2×106个细胞,PBS洗涤1次, 移入eppendorf管,重悬于20mL PBS,加入400mL细胞裂解液(1% NP-40、20 mmol EDTA、50 mmol Tris Cl,pH7.5),混匀,裂解30 min(镜下检查),8 000×g离心5 min,转移上清至另一eppendorf管中,并向其中加入10% SDS 至终浓度为1%,加入RNase A至终浓度为50 mg/L,置56 ℃,2 h;再加入蛋白酶K至终浓度25 mg/L,37 ℃,2 h,沉淀DNA,样品溶于少量TE中,1.5%琼脂糖凝胶(含0.5 mg/L EB),50 V,电泳4 h,紫外灯下照相。
1.6 细胞周期时相中DNA含量的测定
收集细胞1×106个,PBS洗两次, 70%冰冻乙醇固定,4 ℃保存。 经碘化丙啶 ( PI,1g/L) 染色, 在Becton/Dickinson FACS420型流式细胞仪上检测。并根据DNA含量直方图中出现的“亚G1峰”计算凋亡细胞百分数。
, 百拇医药
2 结果
2.1 蟾蜍灵对肿瘤细胞生长的抑制作用
蟾蜍灵处理48 h,明显抑制 MGc-803细胞生长,并随着药物浓度的增加,抑制率也增大,蟾蜍灵对MGc-803 的IC50值在0.01~0.1 mmol/L之间(表1)。
2.2 蟾蜍灵诱导肿瘤细胞凋亡
2.2.1 细胞形态学改变:倒置显微镜下,MGc-803细胞呈梭形或多边形,加入蟾蜍灵,细胞变圆,细胞内颗粒增多,细胞透明度下降,体积缩小, 可见凋亡小体形成,分布于细胞残体周围;爬片细胞经吖啶橙染色,在荧光显微镜下可见,对照组细胞核呈黄绿色,胞浆染成橙红色;而药物处理组细胞变圆,核碎裂,胞浆橙红色变浅(图1);电镜照片(图2)显示:凋亡早期,染色质发生边移现象,沿核膜内侧分布,细胞器完整;后期,核膜瓦解,核凝缩,出现变性空泡,细胞器减少,细胞尚保持结构。
, 百拇医药
2.2.2 DNA凝胶电泳观察到典型的DNA 梯状带:细胞凋亡时,由于核酸内切酶活化,染色质在核小体之间断裂,产生寡聚核小体, 电泳带谱表现为特征性的梯状带(DNA ladder)。0.01和0.1 mmol/L 蟾蜍灵处理MGc-803,在48 h出现清晰的DNA梯状带,而未处理的对照组细胞不显示DNA梯状带。
2.2.3 流式细胞仪分析结果:不同浓度蟾蜍灵处理细胞,一定时间后,出现相当比例的DNA含量小于二倍体的亚G1凋亡峰,在6、12、24和48 h,凋亡率逐步升高(表2),细胞周期也发生明显变化,G1期细胞数量逐渐减少(图3), 同期台盼蓝染色阳性细胞数分别为2.1%、4.7%、8.1%和12.3%。
图 1 吖啶橙染色示细胞染色质和RNA 的变化
Fig 1 The changes of chromatin and RNA
, 百拇医药
stained by acridine orange
A control ;B Treatment with 0.1 m mol/L bufalin for 24h;
fluorescein microscopy ×200
图 2 电镜观察细胞超微结构的变化
Fig 2 MGc-803 cells treated with bufalin (2b 2c EM
7500)compared with control cells(2a EM 7500)
Apoptotic cells shrinked cell became smaller chromatin accumu-
, 百拇医药
lated under nuclear membrane (2b)the electron density of apoptotic
tumor cells increased apoptotic body formed(2c)
图 3 流式细胞术分析细胞周期的变化
Fig 3 The changes of cell cycle analysed
by flow cytometry
表 1 蟾蜍灵抑制胃癌细胞MGc-803 生长
Table 1 Growth inhibition of gastric cancer cells
, 百拇医药
induced by bufalin concentration
Avalue
rateofinhibition
(μmol/L)
bufalin
control
blank
(%)
0.001
1.32±0.14
1.43±0.10
, 百拇医药 0.44±0.06
11.1
0.01
1.03±0.13*
40.4
0.1
0.77±0.07**
66.7
1.0
0.48±0.07**
96.0
表 2 蟾蜍灵作用胃癌细胞MGc-803 调亡率
, 百拇医药
Table 2 Apoptotic rate of gastric cancer cells induced by bufalin concentration(m
mol/L)
apoptoticrate(%)
rateofinhibition
0.00
1.43±0.04
2.21±0.07
4.61±0.21
6.03±0.21
0.01
, 百拇医药
6.15±1.13*
10.22±0.69#
16.74±0.74#
26.24±1.48#
0.10
10.59±0.90**
21.01±1.82#
32.43±1.12
43.17±1.31
3 讨论
, 百拇医药
蟾酥是我国的传统中药,临床治疗胃癌获得了显著疗效,胃癌不仅是细胞增殖和分化异常的疾病,也是细胞凋亡异常的疾病[5],因此,筛选能够诱导胃癌细胞凋亡的有效成分,具有重要的实用价值。
我们实验发现蟾蜍灵与MGc-803细胞共育时,细胞增殖明显受到抑制,细胞脱落圆形小体,数目随时间递增,而台盼蓝染色阳性细胞保持较低的水平;经形态学、细胞学和DNA片段检查等多方面证实, 蟾蜍灵可有效地诱导胃癌细胞凋亡,凋亡早期,凋亡小体(apoptotic body) 及细胞残体为台盼蓝拒染,后期,阳性细胞数增多可能与凋亡后的继发性坏死有关。蟾蜍灵作用于MGc-803细胞时,G1期细胞数目下降,在DNA直方图上观察到典型的亚G1峰,可见蟾蜍灵主要诱导G1期细胞凋亡。
蟾蜍灵抑癌作用的机制还不是很清楚。Numazawa等[6]报道低浓度(0.001-0.005 mmol/L)蟾蜍灵能诱导肿瘤细胞分化;Mashuda等[7]用1 mmol/L蟾蜍灵处理白血病HL60细胞15 min,然后撤药,继续培养15 h, 检测到细胞生存率下降和DNA梯形条带, 提示蟾蜍灵处理后, 细胞凋亡信号立即启动 ;Hashimoto等[8]报道蟾蜍灵降低细胞拓扑异构酶Ⅱ的活性,并检测到DNA裂解,用0.1 mmol/L蟾蜍灵预处理HL60细胞6 h,能增强顺铂和维甲酸的诱导凋亡作用;Jing等[9]用1mmol/L 蟾蜍灵处理人正常单核细胞和多形核细胞24 h,没有观察到细胞凋亡,蟾蜍灵选择性地抑制肿瘤细胞生长;另外,Lee等[10]发现蟾蜍灵能抑制血管的生成, 抑制肿瘤的血管生成也是其抗癌机制的重要方面。本研究首次发现,0.01 mmol/L及以上浓度的蟾蜍灵能有效地诱导胃癌细胞凋亡,扩展了蟾蜍灵的抗癌癌谱。
, http://www.100md.com
总之,本研究发现蟾蜍灵是一种有效诱导低分化胃腺癌细胞凋亡的药物,并具有细胞周期特异性,蟾蜍灵诱导胃癌细胞凋亡的机制有待于进一步研究。
参考文献:
[1] 杨素娟.蟾蜍及蟾酥的临床应用与研究进展[J].中医药信息,1995,( 5) :12-13.
[2] 田普训等.蟾酥脂质体对人膀胱移行细胞癌BIU-87 作用的体外实验研究[J].中华泌尿外科杂志,1994,15(6):432-435.
[3] Racker DK, Hoffman RE, Fortner JG.Transmission electricmicroscopy :methods of application[M]. Illinois: Charles C Thomas Publisher,1983,14.
, 百拇医药
[4] 温汉平,王小宁,孙华蕴.肿瘤细胞体外药敏试验MTT分析法[J].中华肿瘤杂志,1993,15(6):470-471.
[5] Waston A J M. Necrosis and apoptosis in the gastrointestinal tract[J].Gut,1995,37:165-168.
[6] Numazawa S,Inoue N,Nakura H,et al.A cardiotonic steroid bufalin- induced differentiation of THP-1 cells[J].Biochem Pharmacol,1996,52(2):321-329.
[7] Mashuda Y,Kawazoe N,Nakajo S,et al.Bufalin induces apoptosis and influences the expression of apoptosis- related genes in human leukemia cells[J].Leuk Res,1995,19(8):549-556.
, 百拇医药
[8] Hashimoto S,Jing Y, Kawazoe N, et al. Bufalin reduces the level of topoisomerase Ⅱ in human leukemia cells and affects the cytotoxicity of anticancer drugs[J]. Leuk Res,1997, 21(9): 875-883.
[9] Jing Y,Ohizumi H,Kawazoe N,et al. Selective inhibitory effect of bufalin on growth of human tumor cells in vitro:association with the induction of apoptosis in leukemia HL60cells[J]. Jpn J Cancer Res,1994,85(6):645-651.
[10] Lee DY,Yasuda M,Yamamoto T,et al.Bufalin inhibitits endothelial cell proliferation and angiogenesis in vitro[J].Life Sci,1997,60(2):127-134.
1999-09-04
2000-01-29, 百拇医药